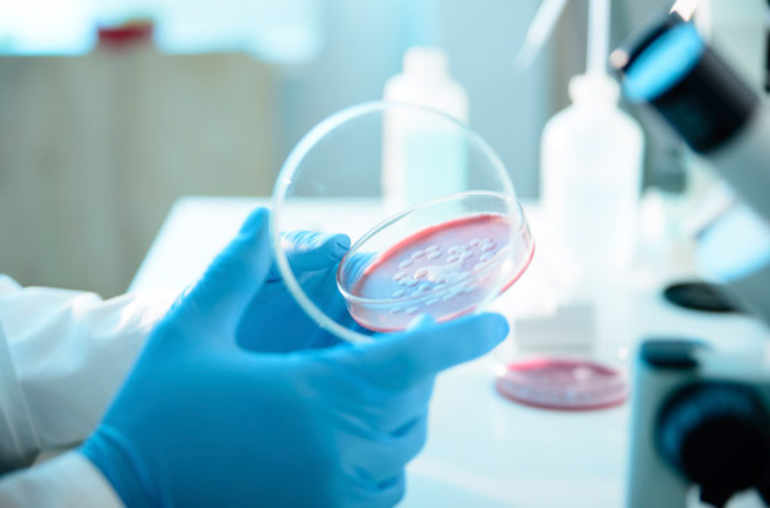

Notre intestin à l'origine de certaines dépressions
L'expérience rapportée dans Nature Communications1 a certes été menée sur des rongeurs, mais elle pourrait probablement se vérifier chez les êtres humains, dans la mesure où le modèle mis en œuvre est très représentatif de ce qui se passe chez l'Homme.
Les chercheurs de l'Université McMaster à Hamilton (Ontario, Canada) ont utilisé un modèle expérimental très réputé. Celui-ci associe le stress provoqué par la séparation des souriceaux d'avec leur mère peu après leur naissance, avec l'anxiété, voire la dépression, qui en découlent ultérieurement.
Dans un premier temps, Premysl Bercik et ses collègues à l'Institut de recherche en santé digestive ont soumis un lot de souris «normales» (c'est-à-dire en bonne santé et dotées d'une flore intestinale – le microbiote – riche et complexe) à un stress néonatal. Pour ce faire, ils les ont privées de leur mère trois heures par jour durant leurs trois premières semaines de vie.
Les chercheurs ont pu dès lors vérifier que ces souris étaient devenues anxieuses et avaient manifesté un comportement typiquement dépressif. Leur taux de corticostérone, l'une des hormones typiques du stress, s'est en outre révélé être 1,9 fois plus élevé que celui de souris identiques laissées avec leur mère et servant de contrôle (en accord avec ce que l'on peut attendre de ce modèle expérimental).
Mieux: comparée à celle des animaux de contrôle, la composition de leur microbiote a été sensiblement modifiée dès la quatrième semaine et jusqu'à la vingtième semaine de vie, avec jusqu'à 45% d'espèces microbiennes différentes!
Des souris stériles bien solides
Les chercheurs ont ensuite répété l'expérience, mais cette fois avec des souriceaux nés dans un environnement complètement stérile. Leur intestin était donc dépourvu des milliards de bactéries qui d'ordinaire, après la naissance, le colonisent peu à peu pour constituer le microbiote.
Une fois soumises au stress de la séparation maternelle à la naissance, le taux de corticostérone de ces souris s’est avéré être beaucoup plus élevé (2,3 fois) que chez les mêmes souris «stériles» n'ayant pas subi de stress néonatal. En revanche, le comportement ultérieur de ces souris dépourvues de microbiote n'a pas du tout été altéré par la séparation maternelle, à en juger par les tests classiques de mobilité et de comportement auxquels les chercheurs les ont soumises.
En tout cas, ce comportement n'a révélé ni l'anxiété ni la tendance à la dépression remarquées lors de la première expérience avec des souris exposées aux microbes ambiants. Comme si l'absence de microbiote chez ces souris les mettait à l'abri de la dépression consécutive au stress périnatal, ce qui avait de quoi interpeller les chercheurs. Pour en avoir le cœur net, les médecins canadiens ont voulu aller plus loin et se sont alors livrés à une expérience audacieuse, dans le droit fil de ce que l'on a entrepris récemment chez des hommes et des femmes souffrant d'une dangereuse maladie intestinale, Clostridium difficile, qu'une greffe de matière fécale avait sauvés.
Au cours de cette troisième expérience, l'équipe du professeur Bercik a ainsi transféré le contenu de l'intestin des souris adultes de contrôle dans l'intestin de leurs congénères stériles séparées de leur mère à la naissance. Et là, autre surprise: alors que la flore intestinale et l'activité métabolique de ces «receveurs» se modifiaient rapidement en quelques semaines, ces souris naguère stériles et sans soucis commençaient à manifester de l'anxiété et une sorte de dépression. A contrario, si la greffe de microbiote s'effectuait à partir de souris séparées de leur mère à la naissance au profit de souris stériles non stressées, aucun changement n'était mis en évidence.
L'action des microbes intestinaux sur le cerveau
Ces constatations un peu contradictoires font dire aux chercheurs que, dans la genèse future d'une anxiété ou d'une dépression, les facteurs microbiens jouent un rôle sans doute aussi important que l'état psychique de l'hôte (stressé ou non à la naissance) qui reçoit ce microbiote.
Ainsi, le stress périnatal altère très certainement le fonctionnement et la réactivité de l'intestin, et est donc capable de modifier le microbiote, ce qui en retour altère les fonctions psychiques et le comportement. C'est la première fois – écrivent les chercheurs – qu'on met en évidence la contribution décisive, dans le comportement de ces souris modèles, du contenu de la flore intestinale.
Il se confirme donc que l'axe de communication entre le cerveau et l'intestin, dont on sait qu'il est entouré d'un réseau de neurones considérable (d'où le qualificatif de deuxième cerveau) est profondément affecté par le contenu du microbiote.
«Il serait intéressant de déterminer – ajoute Bercik – si les résultats de cette expérience peuvent s'appliquer à l'Homme. Et de voir par exemple si l'on pourrait déceler des profils anormaux dans la composition du microbiote des patients souffrant de dépression ou d'anxiété».
En tout état de cause, cette étude jette une lumière nouvelle sur la dynamique qui lie le contenu microbien de l'intestin au fonctionnement du cerveau, et montre qu'une modification même mineure du microbiote ou de son métabolisme (par exemple en cas de stress à la naissance) peut avoir d'importantes répercussions sur le comportement de l'individu à l'âge adulte.
_________
Référence

La dépression post-partum chez les pères, un mal méconnu
Journée mondiale de la santé mentale: la prédisposition génétique de la dépression chez les femmes

Dépression
La dépression peut se manifester par une tristesse, un manque de plaisir et d'énergie, mais aussi par des changements dans le sommeil, l'appétit ou le poids.


